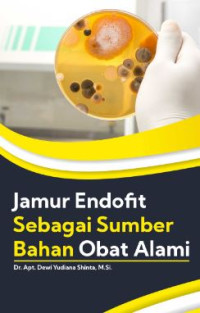
Image of JAMUR ENDOFIT SEBAGAI SUMBER BAHAN OBAT ALAMI

Buku Teks
JAMUR ENDOFIT SEBAGAI SUMBER BAHAN OBAT ALAMI
Tidak Tersedia Deskripsi
Ketersediaan
#
My Library
615.3 DEW j
615.3 DEW j
Tersedia
Informasi Detail
| Judul Seri | - |
|---|---|
| No. Panggil | 615.3 DEW j |
| Penerbit | Yogyakarta : Deepublish, 2021 |
| Deskripsi Fisik | vi, 43 hlm; 15,5 x 23 cm |
| Bahasa | Indonesia |
| ISBN/ISSN | 9786230226458 |
| Klasifikasi | 615.3 |
| Edisi | - |
| Subjek | Farmasi |
| Pernyataan Tanggungjawab | - |
Lampiran Berkas
Tidak Ada Data
Komentar
Anda harus masuk sebelum memberikan komentar